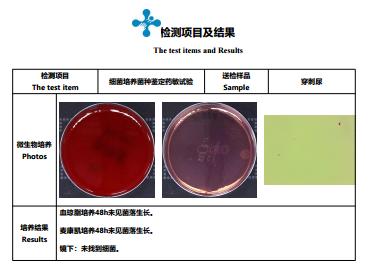
​猫咪“甜蜜的负担”，当患有糖尿病时，应如何治疗？

猫咪无忧无虑的生活,在很多人眼中是超级幸福的, 不仅餐食按时送到嘴边不说,还有专人负责铲屎 ,各样玩具更是应有尽有,令人羡慕极了!
而最近猫咪糖尿病,却逐渐出现在养宠家庭的视线中,日益严重。
没错,不要以为只有人才会得糖尿病 ,
其实猫咪也是会得糖尿病 。
今日就为大家介绍一则宠爱国际 猫科、内科专家「张英」 医生接诊的 「糖尿病合并子宫蓄脓感染」病例 ,一起来了解下。

〖 宠 爱 国 际 病 例 本 〗

图|网络
- 名字:咔咔
- 性别:女孩
- 年龄:7岁
- 品种:中华田园猫
主诉病史
家长发现家里的中华田园猫 阴门处流脓性分泌物 ,近一段时间饮水多,排尿多。精神食欲未见明显异常,未免疫,驱虫不详。
医院检查
临床检查: 腹部皮肤变薄,腹部血管纹理清晰可见,腹部变大,阴门处流脓性分泌物。
系统检查:
1、体型正常
2、听诊心、肺
3、免疫完全,精神状态尚可
实验室检查:
血常规检查

生化检查

血气化验

尿检:尿糖+++,尿比重1.008


PCR猫杯状病毒感染阳性
DR检查


B超检查

初步诊断
猫糖尿病、子宫蓄脓感染
合并杯状病毒感染
治疗方案
控制好血糖后绝育手术
猫咪较少发生糖尿病时的慢性并发症,与狗狗不同,猫咪不发生糖尿病性白内障。
猫糖尿病常见的形式是IDDM,当食物和降糖药物对IDDM无治疗效果时,必须用外源性胰岛素控制血糖,并防止酮症酸中毒。
患猫需要控制好血糖的后,做子宫病理性摘除术,术后对伤口护理,并控制好血糖 ,术后第六天,血糖控制良好,伤口愈合良好。
病例讨论
猫咪糖尿病
糖尿病可见于任何年龄,但多数糖尿病猫在诊断时都大于9岁(平均为10岁)。 平均每400只猫即有1只发生。糖尿病确切病因不清,但中年肥胖猫常见 。雄性猫发生率是雌性猫的2倍。 胰腺先前的疾病、遗传、激素失衡、感染和一些药物也具有一定的作用 。
如果发现猫咪患上糖尿病,要及时送医治疗 , 听取医生的治疗方案。
另外铲屎官需要正确的方法去照顾它,要让猫咪补充足够营养直至身体状况稳定之后, 要细心照顾,定期注射胰岛素,日常饮食可选择处方粮或者低碳水化合物 ,并定期回诊,记录好猫咪的食欲、体重及喝水等情况,与医生进行沟通讨论。
除此之外, 需要监控体重,超重而患病的猫咪需要减肥 ,并随着猫咪体重的变化,调节胰岛素注射量。
猫咪的糖尿病和人类一样,都属于慢性疾病 ,铲屎官必须遵照医生制定的饮食量,时间及食物等,来维持猫咪的健康,切记不要擅自更改饮食量或剂量哦。
更多治疗实例
宠爱国际猫咪友好医院,让猫咪看病不再恐惧↓
17岁,雄性。猫咪已绝育、频繁呕吐,没精神有一周的病程 家长发现情况后,带来来就诊 有2级肾衰病史。经综合检查诊断为:4级肾衰 结石 肝损伤 存在糖尿病并发症和慢性炎症 脱水10%{病危} 结膜黄染 触诊单侧肾萎缩。24小时特护,纠正脱水调整体征,控制糖尿病并发症,恢复良好。


宠爱国际内分泌科
该科室承担内分泌代谢病的诊疗、保健任务,拥有日本富士AU10V动物内分泌分析仪等设备。宠爱国际是国内较早设立小动物内科专科门诊的医院,在小动物内科诊疗领域享有盛名 。特色门诊包括内分泌腺体肿瘤摘除手术,肾上腺肿瘤,甲状腺肿瘤,副甲状腺肿瘤,胰脏肿瘤摘除,内分泌疾病药物调控,生长激素不足/过多,甲状腺功能低下/亢进,库兴氏症/爱迪生氏症,糖尿病调理,肾上腺脑积水门诊等,同时充分发挥医院的综合优势,组建“多学科合作综合治疗团队”,如与普外科、内镜中心、麻醉科、ICU等多团队合作开展了外科治疗糖尿病及其它内分泌疾病并发症;与康复理疗科合作开展肥胖、糖尿病、酮症酸中毒等的营养治疗;与泌尿外科多团队合作,在肾上腺病变的筛查及内分泌高血压的诊治方面成效明显;与超声诊断科、磁共振与CT影像中心、病理科合作,在甲状腺结节的良恶性鉴别方面进一步形成特色;与神经外科合作, 提高了垂体疾病的诊治水平;与普外科合作,联合治疗胰腺内分泌肿瘤等。联合我院外科(胃肠道内分泌肿瘤、甲状腺肿瘤,甲状旁腺肿瘤)、泌尿外科(肾上腺肿瘤)、脑外科(垂体肿瘤)的综合优势,建立 “内分泌肿瘤学科群”,提高了临床处理内分泌疾病的能力。 在各项疾病诊疗的过程中,良好的疗效显示出宠爱国际内分泌诊疗中心的诊治特色优势 。
宠爱国际猫科
该科室得益于医院专业的猫病诊断及照护能力,包括猫的慢性口炎及慢性肾衰竭、异物手术、血球血液及气体分析、预防医学及老年猫医学等,给爱猫提供完善的医疗照顾, 致力于猫科医疗质量与福利,并针对猫咪特质来教育猫咪家长对于看诊流程的配合,让猫咪能快乐上医院并将紧迫性降至更低 。
预防方案及康复后保健措施
猫咪的糖尿病都有哪些症状表现?
❗️经常口渴,饮水量异常增多
❗️日渐消瘦,体重大幅下降
❗️尿量增加
❗️食欲良好,食量增加
❗️精神不济,活动量下降
❗️毛发失去光泽,呈现蓬乱状
❗️步行困难,呈现跖行状态
❗️一般跳跃或攀爬有难度
什么样的猫咪会更容易患有糖尿病呢?
❗️肥胖猫咪: 拥有不良的饮食习惯,活动量少,会导致猫咪对胰岛素的敏感性下降;
❗️老年猫咪: 9岁以上猫咪更常见,因为猫咪对胰岛素的利用能力下降;
❗️去势的公猫 :激素水平的变化会导致肥胖、以及增加胰岛素的抵抗。

当发现猫咪患有糖尿病,家长可以做什么?
糖尿病的治疗主要以缓解症状、维持合理的范围的血糖值、预防或延迟并发症的发生为治疗目的。
日常做好药物治疗+良好的生活方式管理。
❗️维持饮食平衡:科学喂养,为猫咪选择合适的食物。
❗️保持适量活动:多陪伴猫咪,鼓励和引导猫咪活动。
❗️监控体重:定期监测体重,了解猫咪近段时间体重变化。
❗️定期体检:定期体检是对疾病早发现、早治疗最好选择。
好的,谢谢医生。
主治医师

大部分糖尿病猫咪是需要终生治疗 ,但也有部分猫咪经药物治疗和良好生活管理后,依旧可以拥有和普通猫咪同样幸福的喵生。
各位家长们还需摆正心态,给予猫咪格外的关心和爱护哦 。